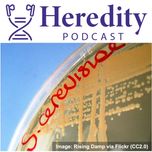

Share
Heredity Podcast
Sex in a warming world: temperature and meiosis
•
Organisms are sensitive to temperature, but reproduction is likely to be affected at lower temperatures than survival. We're joined by Jessica McNeill & Caiti Smukowski Heil to talk about their work on meiosis in yeasts.
More episodes
View all episodes

American mink & the use of pangenomes
28:36|A team from universities in Connecticut tell us about their use of pangenomes to examine the status of mink populations in Florida, and an innovative programme that's training the next generation of researchers.
Where your publication fees go, with Jonathan Pettit
13:07|Genetics Society Vice President Jonathan Pettitt discusses what Heredity's publication revenue is used for, and the scientific community benefits of publishing in society journals.
Student Paper Prize 2025 - Inbreeding in European Barn Owls
19:18|The Student Paper Prize for 2025 was won by Eléonore Lavanchy. Eléonore discusses her work, the winning paper and inbreeding in European Barn Owls.
PopGroup 59 - part 2
23:20|Episode 2/2 from the 59th Popgroup meeting in Lille. Plenary speakers Claire Mérot and Denis Roze discuss their experience of the conference and the content of their talks.
PopGroup 59
23:00|Episode 1/2 from the 59th Popgroup meeting in Lille. Plenary speaker Florencia Camus talks about her experience of the conference and the content of her talk.
Sexual selection in a warming world
25:28|Reproduction involves decisions about when to mate and who with. We know that high temperatures affect fertility, but how does this affect mating decisions and sexual selection within populations? Tilly Pembury Smith and Rhonda Snook tell us about their work using fruit files.
Resisting parasitoids: beetle v wasp
17:33|Parasites and parasitoids are large drivers of evolutionary change. We hear from Peter Hambäck (Stockholm University) about his work on how beetle larvae combat a parasitoid wasp that wants to lay its eggs inside them.
The consequences of invasion
24:33|We often hear that invasive species are bad for the ecosystems they invade, but the consequences can seem remote and hard to grasp. In this episode we hear from Nitin Ravikanthachari and Carol Boggs about their study system where an invasive plant has very tangible effects for a native butterfly.